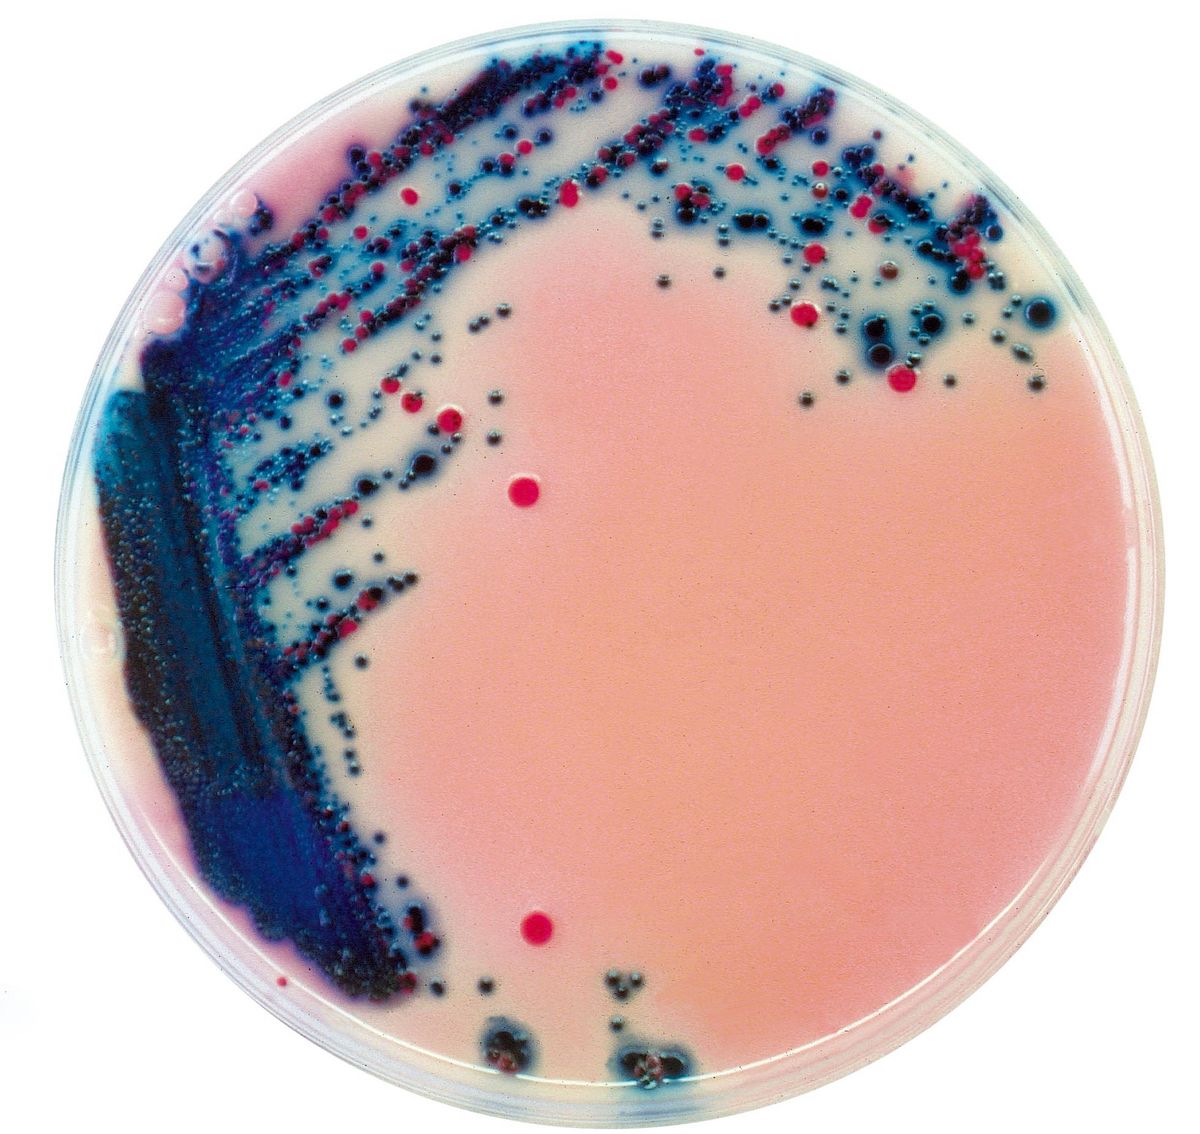
Rambach™ Agar - 5000 ml

RR703-25
For detection and isolation of Salmonella spp. in food samples
Package size: 25 L
DKK 9.750,00
DKK 2.625,00
Not in stock, delivery 1-2 weeks
Chromogenic medium for detection and isolation of Salmonella species in food samples.
The product is composed of a powder base (B) and one liquid supplement (S).
MEDIUM PERFORMANCE:
1. Reliable: the first commercially available (1989) chromogenic medium, is still successful today, thanks to its performance.
2. Very high sensitivity: Salmonella → 93,9 %*
*Sensitivlity from scientific study: Gruenewald, R. et al. 1991. Use of Rambach Propylene Glycol Containing Agar for Identification of Salmonella spp. J.C.M. 29: 2354-2356.
3. Intense red colouration for easy reading, compared to other chromogenic media.
4. Fast results: particularly useful in case of a sudden, dangerous outbreak of Salmonella food poisoning.
5. High specificity / Lower worlkload: The conventional media for the detection of Salmonella by H2S character has very poor specificity, creating an abundance of false positives (Citrobacter, Proteus, etc.) among the rare real positive Salmonella. The workload for unnecessary examination of suspect colonies is so high that the real positive Salmonella colonies might often be missed in routine testing. Because of their poor specificity, conventional media require tedious examination of at least 10 colonies per suspected sample. On the contrary, Rambach™ Agar eliminates most of those false positives and allows technicians to focus on the real contaminated samples.
TYPICAL APPEARANCE OF MICROORGANISMS:
Salmonella → red
Many Coliforms → blue, violet
Proteus, etc. → colourless
Despite its early discovery in the 1880’s, Salmonellaremains a major worldwide pathogen and one of the most common food-borne poisons.
Mainly due to contamination in the food chain and/or during food-production processes, Salmonella commonly induces enteric illness whose major symptoms are abdominal cramps, diarrhea, nausea, vomiting. More severe cases, for instance typhoid cases or infections in immuno-depressed patients, can lead to body dehydration with renal failure or bacteraemia.
This underlines the importance of a continuous control of Salmonella along the entire food production chain.
Also availbale in 25 L (RR703-25).